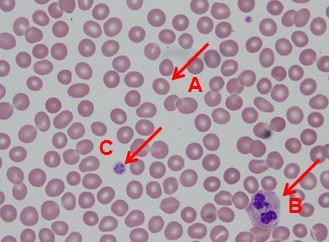

Which cell is a platelet?
- A
- B
- C
Which cell is a platelet?
- A
- B
3. C
Describe the process of megakaryopoiesis
HSC -> myeloid SC -> committed progenitor -> megakaryoblast -> megakaryocyte
- Endomitosis results in polyploid, lobulated eccentric nucleus (characteristic of mature megakaryocyte)
- Megakaryocyte undergoes shedding (ctyoplasmic granulation and fragmentation) to create platelets

What is this?

Platelets forming on the periphery of a megakaryocyte
- Large cell (about 50x RBC!)
- Eccentric multilobulated nucleus
- Granular cytoplasm
(Normally about 0.1% of all nucleated BM cells)
How many platelets are made per megakaryocyte?
How many made per day?
1000-5000 platelets/megakaryocyte
10^11 each day
Where do platelets get sequestered?
Consequences?
1/3 of platelet mass is sequestered in the spleen
- Liver dz -> splenomegaly -> increased sink size -> decreased platelet count
What is thrombopoietin? Where is it made?
- Primary hematopoietic GF regulating megakaryocyte growth and number
- Made in liver (mostly) and kidneys
Mechanism of TPO signaling?
- TPO binds c-MPL on megakaryocytes and platelets
- Platelet/megakaryocyte mass serves as skin: plasma levels increased with low platelet count, driving increased production
What is the structure of a platelet?
- Diameter
- Nucleus?
- Shape
- Volume
- 1-4 um
- Anucleate
- Discoid
- MPV: 7-11 fL
What membrane glycoproteins do platelets have?
- GPIIb-IIIa: fibrinogen receptor
- GPIb-IX-V: von Willebrand factor receptor
- GPIa-IIa, GPVI: collagen receptors
What granules do platelets have?
Alpha granules:
- Larger and more abundant
- vWF, platelet factor 4, fibrinogen, factor V
Dense granules (delta):
- About 10x fewer than alpha
- Small mcls: ADP, ATP, serotonin, Ca, Mg
What is GPIIb-IIIa?
- Amount
- Function
- Targeting drugs
- Associated diseases
- Most abundant platelet membrane protein (50-80K)
- Platelet activation -> conformational change with high affinity for fibrinogen -> aggregation
- Target of drugs in CAD: abciximab, tirofiban, eptafibatide
- Congenital defects: Glanzmann thrombasthenia
The blood protein fibrinogen forms bridges between platelets by binding to what?
GpIIb/IIIa proteins
- Mediates platelet aggregation

What is GPIb-IX-V?
Principal receptor for vWF
- vWF binds to subendothelial collagen
- GPIb-IX-V tethers platelets via vWF
- Binds other proteins: thrombin, P-selectin
What disease is associated with GP Ib-IX-V? Characteristics?
Congenital defects: Bernard-Soulier
- Giant platelets
- Thrombocytopenia
- Bleeding
What are the steps in the formation of a platelet plug?
Adhesion
Activation
- Shape change
- IIb-IIIa activation to fibrinogen receptor
- Secretion/release reaction (ADP, fibrinogen, vWF, calcium, TXA2)
- Phosphatidylserine expression (acceleration of Xase by 20M; acc of prothrombinase by 300K)
Aggregation

Overall schematic of secondary hemostasis (picture)

What is a “qualitative” platelet disorder?
Have enough platelets, but they’re not functioning correctly
What are some inherited qualitative platelet disorders?
- Glanzmann thrombasthenia
- Bernard-Soulier syndrome
- Storage pool diseases
- Non-classic disorders more common, less defined
Characteristics of Glanzmann thrombasthenia?
Qualitative platelet disorder
- Abnormal GP IIb/IIIa
- Purpura, epistaxis, gingival bleeding, and menorrhagia
- Defective aggregation to all agonists except ristocetin
Characteristics of Bernard-Soulier syndrome?
Qualitative platelet disorder
- Abnormal GP Ib-IX-V
- Giant platelets and thrombocytopenia
- Decreased aggregation with ristocetin; normal to others
Characteristics of storage pool diseases?
Qualitative platelet disorder
- Alpha-granule deficiency: gray platelet syndrome (alpha granules are most prominent component of platelets)
- Dense-granule deficiency: Hermansky-Pudlak
What may cause acquired platelet dysfunction?
- Aspirin, NSAIDs
- Many other drugs: beta-lactam Abx, CCBs, SSRIs
- Renal failure
- Liver dz
(- Cardiopulmonary bypass)
(- MPDs/MDS)
(- Dysproteinemias)
How does diabetes affect platelet function?
Increases reactivity
What types of bleeding symptoms typically characterize platelet disorders?
Mucocutaneous bleeding










